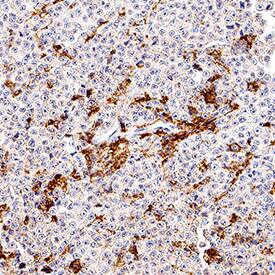

Human Fc gamma RIIIA/CD16a Antibody
R&D Systems, part of Bio-Techne | Catalog # MAB107512


Key Product Details
Species Reactivity
Applications
Label
Antibody Source
Product Specifications
Immunogen
Gly17-Gln208
Accession # P08637
Specificity
Clonality
Host
Isotype
Scientific Data Images for Human Fc gamma RIIIA/CD16a Antibody
Fc gamma RIIIA/CD16a in Human PBMCs.
Fc gamma RIIIA/CD16a was detected in immersion fixed human peripheral blood mononuclear cells (PBMCs) (positive staining) and A549 human lung carcinoma cell line (negative staining) using Rabbit Anti-Human Fc gamma RIIIA/CD16a Monoclonal Antibody (Catalog # MAB107512) at 3 µg/mL for 3 hours at room temperature. Cells were stained using the NorthernLights™ 557-conjugated Anti-Rabbit IgG Secondary Antibody (red; NL004) and counterstained with DAPI (blue). Specific staining was localized to cell surface. Staining was performed using our protocol for Fluorescent ICC Staining of Non-adherent Cells.Fc gamma RIIIA/CD16a in Human Spleen.
Fc gamma RIIIA/CD16a was detected in immersion fixed paraffin-embedded sections of human spleen using Rabbit Anti-Human Fc gamma RIIIA/CD16a Monoclonal Antibody (Catalog # MAB107512) at 3 µg/mL for 1 hour at room temperature followed by incubation with the Anti-Rabbit IgG VisUCyte™ HRP Polymer Antibody (VC003). Before incubation with the primary antibody, tissue was subjected to heat-induced epitope retrieval using Antigen Retrieval Reagent-Basic (CTS013). Tissue was stained using DAB (brown) and counterstained with hematoxylin (blue). Specific staining was localized to lymphocytes. Staining was performed using our protocol for IHC Staining with VisUCyte HRP Polymer Detection Reagents.Detection of Fc gamma RIIIA/CD16a in Human PBMCs by Flow Cytometry.
Human peripheral blood mononuclear cell (PBMC) lymphocytes were stained with Rabbit Anti-Human NCAM-1/CD56 Alexa Fluor® 647-conjugated Monoclonal Antibody (FAB24086R) and either (A) Rabbit Anti-Human Fc gamma RIIIA/CD16a Monoclonal Antibody (Catalog # MAB107512) or (B) Rabbit IgG Isotype Control (MAB1050) followed by PE-conjugated Anti-Rabbit IgG Secondary Antibody (F0110).Applications for Human Fc gamma RIIIA/CD16a Antibody
Flow Cytometry
Sample: Human peripheral blood mononuclear cells (PBMCs)
Immunocytochemistry
Sample: Immersion fixed human peripheral blood mononuclear cells (PBMCs)
Immunohistochemistry
Sample: Immersion fixed paraffin-embedded sections of human spleen
Formulation, Preparation, and Storage
Purification
Reconstitution
Formulation
Shipping
Stability & Storage
- 12 months from date of receipt, -20 to -70 °C as supplied.
- 1 month, 2 to 8 °C under sterile conditions after reconstitution.
- 6 months, -20 to -70 °C under sterile conditions after reconstitution.
Background: Fc gamma RIIIA/CD16a
Fc gamma RIIIa is a low/intermediate affinity receptor for polyvalent immune-complexed IgG. It is involved in phagocytosis, secretion of enzymes and inflammatory mediators, antibody-dependent cytotoxicity and clearance of immune complexes (1, 2). In humans, it is a 50-70 kDa type I transmembrane activating receptor expressed by NK cells, T cells, monocytes, and macrophages (1). Fc gamma RIIIb is highly related, sharing 97% amino acid (aa) identity within the extracellular domain (ECD), but is a GPI-linked receptor expressed on human neutrophils and eosinophils (1, 2). The ECD of Fc gamma RIIIa shares 63%, 61%, 65%, 59% and 58% aa identity with mouse Fc gamma RIV, rat Fc gamma RIIIa, feline CD16, bovine CD16 and porcine Fc gamma RIIIb paralogs, respectively. The Fc gamma RIIIa cDNA encodes 254 aa including a 16 aa signal sequence, 191 aa ECD with two C2-type Ig-like domains and five potential N-glycosylation sites, a 22 aa transmembrane (TM) sequence and a 25 aa cytoplasmic domain. In humans, a single nucleotide polymorphism creates high binding (176V) and low binding (176F) forms that, when homozygous, may influence susceptibility to autoimmune diseases or response to therapeutic IgG antibodies (3, 4). Catalog # 4325-FC is expressed as the 176V isoform of Fc gamma RIIIa. Fc gamma RIIIa surface expression requires interaction of an accessory chain, either the common gamma-chain or CD3 zeta (5, 6). Glycosylation patterns, electrophoretic mobility and binding affinity appear to differ between NK cell and monocyte Fc gamma RIIIa (7). The ECD of both Fc gamma RIIIa and b can be proteolytically cleaved and retain binding activity in soluble form (8-11). In monocytes and macrophages, activation and phagocytosis can trigger Fc gamma RIIIa release (11). Soluble Fc gamma RIII can be detected in normal plasma and is increased in rheumatoid arthritis and in coronary artery diseases (9, 10).
References
- Nimmerjahn, F. and J.V. Ravetch (2006) Immunity 24:19.
- Ravetch, J.V. and B. Perussia (1989) J. Exp. Med. 170:481.
- Wu, J. et al. (1997) J. Clin. Invest. 100:1059.
- Dall’Ozzo, S. et al. (2004) Cancer Res. 64:4664.
- Kim, M.-K. et al. (2003) Blood 101:4479.
- Lanier, L.L. et al. (1989) Nature 342:803.
- Edberg, J.C. and R.P. Kimberley (1997) J. Immunol. 159:3849.
- Li, P. et al. (2007) J. Biol. Chem. 282:6210.
- Masuda, M. et al. (2003) J. Rheumatol. 30:1911.
- Masuda, M. et al. (2006) Atherosclerosis 188:377.
- Webster, N.L. et al. (2006) J. Leukoc. Biol. 79:294.
Long Name
Alternate Names
Gene Symbol
UniProt
Additional Fc gamma RIIIA/CD16a Products
Product Documents for Human Fc gamma RIIIA/CD16a Antibody
Product Specific Notices for Human Fc gamma RIIIA/CD16a Antibody
For research use only